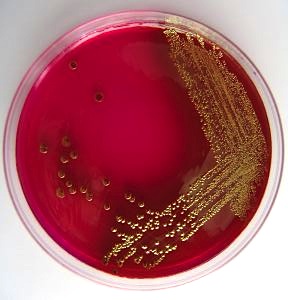
Posiew moczu - wzrost E. coli na podłożu agarowym

Posiew moczu - od pobrania próbki moczu do badania bakteriologicznego i antybiogramu
Posiew moczu jest podstawowym badaniem laboratoryjnym wykonywanym w celu określenia gatunków bakterii występujących w moczu. Badanie polega na pobraniu próbki moczu, która następnie jest umieszczana na specjalnej pożywce. Posiew moczu wykonywany jest w laboratorium mikrobiologicznym. Celem posiewu moczu jest ustalenie rodzaju bakterii i określenie ich lekowrażliwości. Lekowrażliwość stanowi podstawę do wykonania antybiogramu, według którego można stosować antybiotyki.
Właściwy sposób pobrania próbki moczu na posiew jest kluczowym problemem w diagnostyce zakażeń układu moczowego. Pobranie moczu na posiew wykonywane jest według powszechnie przyjętego schematu.
Jak prawidłowo pobrać próbkę moczu na posiew
Za najlepszy mocz do wykonania posiewu uznaje się mocz pobrany z porannej mikcji ze środkowego strumienia. W porannym moczu występuje największe stężenie bakterii czyli szansa na wyhodowanie patologicznych drobnoustrojów jest największa. Pobranie moczu po całonocnym odpoczynku nie jest warunkiem koniecznym do wykonania posiewu. W przypadku pobrania moczu na posiew u pacjenta stosującego antybiotyk konieczne jest zaznaczenie tego faktu na skierowaniu z podaniem nazwy preparatu i daty rozpoczęcia leczenia.
Pobranie próbki moczu ze środkowego strumienia?
Po nocnym odpoczynku należy udać się do łazienki i obmyć ciepłą wodą z mydłem okolicę zewnętrznych narządów płciowych. Nie należy stosować do obmycia środków dezynfekujących. U mężczyzn konieczne jest w czasie mycia odprowadzenie napletka zaś u kobiet zaleca się obmycie okolicy ujścia cewki moczowej i przedsionka pochwy. Okolice intymne oraz ręce powinny być wytarte suchym ręcznikiem.

Fot. Jałowy pojemnik na mocz
Pojemnik na mocz wykorzystywany do posiewu musi być jałowy (do badania ogólnego moczu pojemnik nie musi być sterylny). Jałowe pojemniki na mocz dostępne są w każdej aptece a ich cena nie przekracza 2 PLN.
Do badania oddaje się mocz ze środkowego strumienia o czym wielu pacjentów zapomina podczas pobierania próbki moczu. Pierwsza porcja moczu oddawana jest do muszli klozetowej, następnie niewielka ilość moczu ze środkowej części mikcji - ok. 15 - 20 ml oddawana jest do pojemnika. Pozostałą część moczu oddaje się do muszli klozetowej. Warunkiem pobrania diagnostycznej próbki moczu u mężczyzn jest odprowadzenie napletka, u kobiet mocz powinien być oddany przy rozchylonych wargach sromowych.
Ile mam czasu na dostarczenie proóbki moczu na posiew do laboratorium?
Pojemnik z moczem powinien być szczelnie zakręcony i jak najszybciej dostarczony do laboratorium. W przypadku, gdy nie ma możliwości dostarczenia preparatu natychmiast po pobraniu zaleca się umieszczenie pojemnika w lodówce utrzymującej temperaturę 4°C. W wielu publikacjach za maksymalny czas przechowywania próbki moczu w lodówce uznaje się dwi godziny. Niedopuszczalne jest przechowywanie preparatu w temperaturze pokojowej.
Fot. Szalka Petriego z podłożem agarowym, na którym widoczny jest wzrost bakterii E. coli
Co dalej po pobraniu moczu na posiew?
Dostarczona do laboratorium próbka jest wysiewana na specjalne podłoże mikrobiologiczne, które umożliwia hodowlę bakterii. Po kilku dniach laboratorium wydaje wynik posiewu z załączonym antybiogramem. W przypadku dodatniego posiewu na wyniku wyszczególnione są bakterie występujące w moczu wraz z antybiotykami, na które są wrażliwe.
Polecane artykuły
Posiew moczu - pobranie próbki moczu, transport i wykonanie antybiogramu
Interpretacja badania ogólnego moczu
Diagnostyka i leczenie zapalenia pęcherza moczowego
Zapalenie cewki moczowej - objawy, diagnostyka i leczenie
Zapalenie prostaty - diagnostyka i leczenie zapalenia gruczołu krokowego
Polecane filmy
Zielony laser w leczeniu łagodnego przerostu gruczołu krokowego
Zapalenie pęcherza moczowego - objawy, rozpoznanie i leczenie
Antybakteryjne działanie żurawiny w infekcjach układu moczowego
Cewnik Foley'a - zakładanie cewnika Foley'a
Bakteria Escherichia coli - budowa